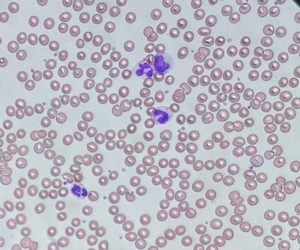
血液検査

各部門のご紹介bumon
臨床検査技術科
臨床検査技術科のご紹介
理念
生命と健康を守る臨床検査技術科の確立と効率的臨床検査技術科体制を目指す
基本方針
- 検査報告値に付加価値を付ける
- 精度管理の充実を図る
- 検査過誤防止に努める
- 患者様、職員から親しまれる臨床検査技術科を目指す
- 臨床検査技術科職員の育成に努める
臨床検査技術科の主な業務
一般検査
尿中に出てくる物質(蛋白、糖等)の定性・定量検査、尿路系疾患を調べる顕微鏡下での細胞・結晶検査、消化管出血の有無を調べる糞便検査、穿刺液(胸水、腹水等)の検査を行います。
血液検査
血液疾患(貧血・多血症・白血病等)、炎症性疾患・出血性疾患の診断や治療のため、血数計数(白血球、赤血球等)検査、血液形態検査、凝固因子検査を行います。
生化学検査
肝疾患、心疾患、腎疾患、消化器系疾患等の診断や治療のため、体内の酵素・脂質・無機質・糖成分・含窒素成分・腫瘍マーカー等の定量分析検査を行います。
微生物検査
肺炎や尿路感染症など様々な感染症の原因となる細菌のグラム染色をしています。また、遺伝子検査(結核菌やSARS-CoV-2)も行っています。
病理検査
当院ではバーチャルスライドシステム(スライド全体の画像を短時間にデジタル画像化するシステム)を使用した手術中の迅速診断を県立中央病院病理診断センターと連携してテレパソロジー(遠隔病理診断)で行います。
輸血検査
安全な輸血ができるよう、血液型や交差適合試験などを検査しています。輸血用血液製剤の発注・保管管理、手術前に患者さん自身より採血した自己血の保管・管理を一元管理しています。
生理検査
生理検査は直接患者さんに接して体内の機能や状態を調べる検査です。心電図検査、肺機能検査、超音波(エコー)検査(心臓・頚動脈・腹部・腎臓)、血圧脈波検査、睡眠時無呼吸検査、聴力検査などを行っています。検査の種類によって一部予約制で行っています。
臨床検査技師による検査説明
臨床検査技術科では「臨床検査技師による検査説明」を行っています。
血液検査・尿検査等について、検査項目の内容(略語・目的・基準値・検査結果の読み方など)について説明をいたします。ただし、診断や治療等に関わる説明はできません。費用は無料です。説明を希望される時はお申し出ください。
臨床検査を終了した検体(残余検体)の業務・教育・研究のための使用についてのお願い
詳しくは添付ファイルをご覧ください。
